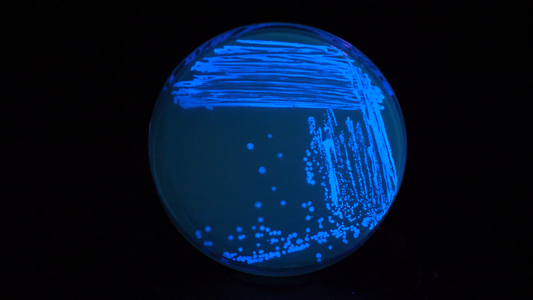

Collection: DNA & Bacteria
-
Electric blue | Plasmid
Regular price $87.50 CADRegular priceUnit price / perSale price $87.50 CAD -
Repressilator v1 | Plasmid
Regular price $87.50 CADRegular priceUnit price / perSale price $87.50 CAD -
DH5A E. coli | Agar Stab
Regular price $72.50 CADRegular priceUnit price / perSale price $72.50 CAD -
Bistable Switch | Plasmid
Regular price $87.50 CADRegular priceUnit price / perSale price $87.50 CAD -
ATF1 - aka Banada Sunday | Plasmid
Regular price $87.50 CADRegular priceUnit price / perSale price $87.50 CAD